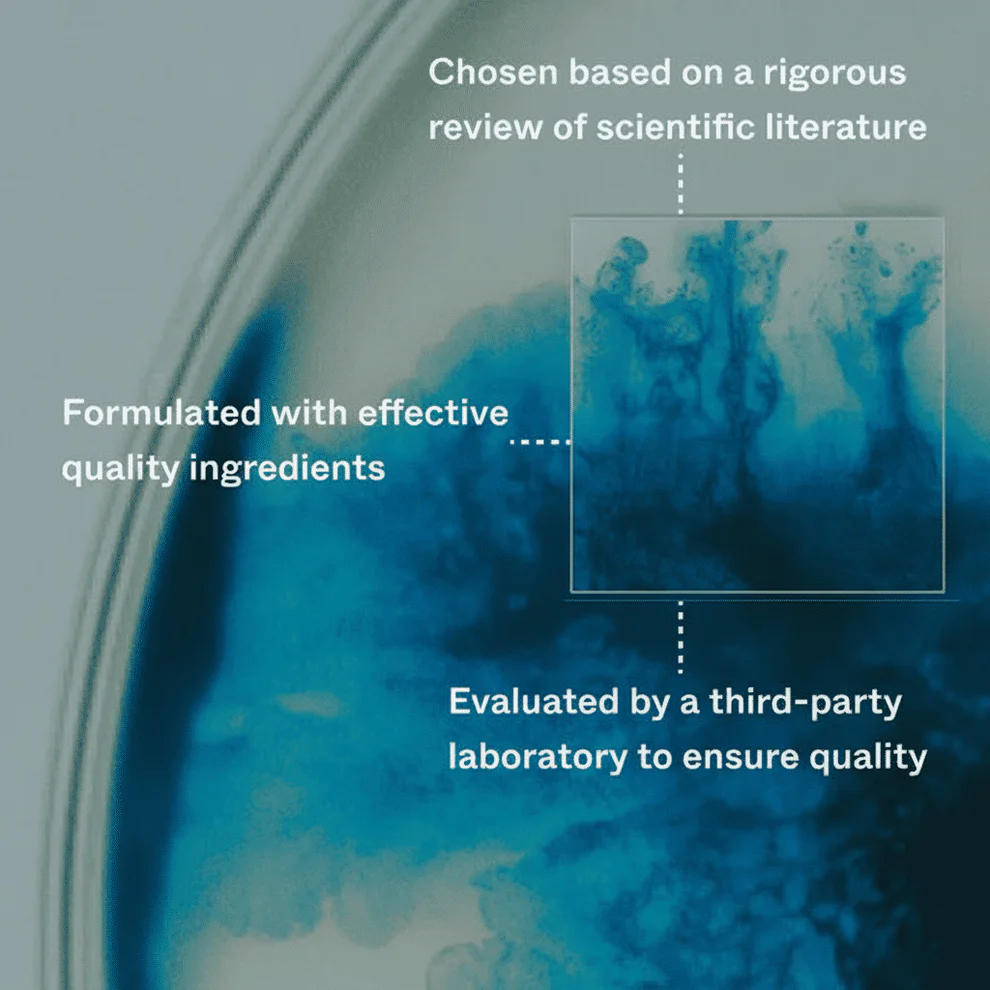

Alisanda™ Advanced Hair Growth Roll-On Serum
Results demonstrated after 150 days
We have developed the Alisanda™ formula, which has been in a proprietary third-party study. Our
Alisanda™ Activation Serum demonstrated the following results:
What’s the cause of hair loss?
Hair loss can be triggered by genetics, hormones, stress, medication, or illness. All of these factors disrupt one crucial thing:
Your hair’s natural growth cycle.
In a healthy scalp, about 90% of hairs should be in the active growth phase, while only 10% rest and shed. When that balance breaks, thinning and hair loss begin.
To stop shedding and regrow hair, two key shifts must happen:
- More hairs need to enter and remain in the active growth phase.
- Fewer hairs should linger in the shedding phase.
You may not be able to change your genetics, but research shows it is possible to rebalance the hair growth cycle. In many cases, this can be achieved by supporting the scalp with the right natural ingredients, without the need for medication.
Hair Growth — Without Drugs
In a clinical study, 30 men and women used our Hair Growth Serum daily for 150 days. The results were powerful:
- saw a visible reduction in hair loss
- reported being satisfied with their results
- 73% achieved a clinically measured increase in hair density
This breakthrough formula helps extend the growth phase and reduce the shedding phase, supporting real, lasting results backed by science.
If you don’t see results in 150 days, we’ll refund you
Step 1: Document your journey
Take a clear photo of the treated area before you begin, then repeat monthly. You’ll be surprised at how much progress shows up when you compare.
Step 2: Apply the Roll-On daily
Use the Hair Growth Roll-On every single day. Consistency is key, even on days you skip other haircare routines.
Step 3: Stick with it for 150 days
Commit to at least 150 days of daily use (about five roll-ons). This is the period where clinical testing showed visible results for of participants.
Every Click Saves with AlisandaShop
AlisandaShop is your trusted global marketplace where quality meets convenience. We bring you a wide selection of trending, practical, and reliable products at fair prices, paired with fast worldwide delivery and secure checkout. Every purchase at AlisandaShop is handled with care to give you a smooth, safe, and enjoyable shopping experience from start to finish.
Shipping Details
We value your time, so every order at AlisandaShop is prepared and shipped within 3 to 5 business days. Standard delivery usually takes 2 to 3 weeks depending on your location. You will receive regular updates at each stage to ensure clarity and peace of mind throughout the delivery process.
Easy Returns
Shopping online should always be risk free. That is why AlisandaShop offers a simple 30 day return policy. If something is not right, you can easily request a return. Customers cover the return shipping cost, and our support team will guide you every step of the way to make the process quick and worry free.
100% Money-Back Guarantee
Your satisfaction means everything to us. All orders at AlisandaShop are backed by a 30 day money back guarantee. If you are not completely happy with your purchase, we will arrange a prompt refund or replacement. Our goal is to provide a dependable shopping experience built on honesty, quality, and customer care.
ABOUT • CONTACT • SHIPPING • RETURNS & REFUNDS • PRIVACY • TERMS
Disclaimer: This product is not intended to diagnose, treat, cure, or prevent any disease. Individual results may vary. This product is designed for general wellness and personal care use only. Please consult a qualified healthcare professional before use, especially if you have a pre-existing medical condition, are pregnant, or are taking medication.